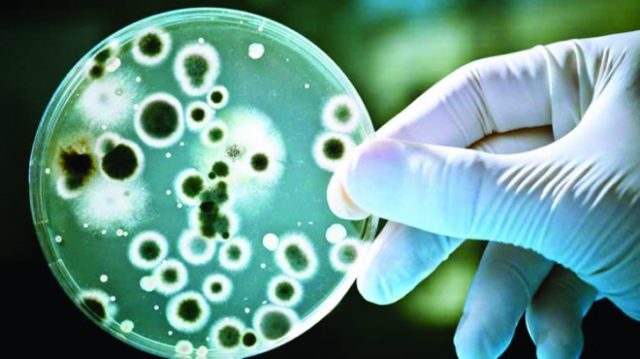

Per l’immaginario collettivo l’infezione della Candida Albicans è attribuibile principalmente al mondo femminile, ma contrariamente a quanto si possa pensare anche gli individui di sesso maschile possono essere esposti e contagiati.
Per l’immaginario collettivo l’infezione della Candida Albicans è attribuibile principalmente al mondo femminile, ma contrariamente a quanto si possa pensare anche gli individui di sesso maschile possono essere esposti e contagiati.
Con l’intento di rendere quanto più chiaro possibile il quadro patologico ed informare la popolazione, vedremo a breve i fattori eziopatologici, i sintomi, i meccanismi di trasmissione e i trattamenti proposti.
Il responsabile della Candida Albicans è un fungo saprofita, tendenzialmente innocuo per l’essere umano, che si nutre di materiale organico in decomposizione. Principalmente risiede nel cavo orale, nel tratto gastrointestinale e nelle zone genitali; questo aspetto fa sì che la Candida A. non sia classificabile tra le Malattie Sessualmente Trasmissibili (MTS) in quanto il fungo vive già all’interno dell’organismo e delle mucose.
Per quanto riguarda l’eziopatogenesi, che è comune per entrambi i sessi, è importante sottolineare che, in condizioni non patologiche, il Sistema Immunitario ci protegge da un’abbondante ed eccessiva proliferazione del suddetto agente patogeno, ma quando questo non avviene (per via di alterazioni dello stesso) il fungo tende a colonizzare l’organismo che risponde con sintomi ed evidenze cutanee che necessitano di adeguati trattamenti.
Vi sono un gruppo eterogeneo di fattori che favoriscono l’infezione:
- Avere rapporti sessuali NON PROTETTI con un partner infetto/a
- Soffrire di immunodepressione (un S.I. debole costituisce un terreno fertile per le infezioni)
- Soffrire di Diabete Mellito (gli alti livelli glicemici favoriscono la proliferazione della Candida A.)
- Uso inadeguato di antibiotici (crea un’alterazione e riduzione della flora batterica)
- Scarsa igiene personale (il fungo tende a crescere in ambienti caldi, pertanto lasciare le zone intime umide o poco asciutte dopo la detersione, può essere considerato un fattore di rischio)
Mentre nei soggetti di sesso femminile la Candida A. si palesa tendenzialmente durante la settimana che anticipa l’arrivo delle mestruazioni con chiazze eritematose, arrossamenti, dolore durante la minzione, pustole ed erosioni cutanee nella zona genitale, negli individui di sesso maschile spesso risulta asintomatica e di conseguenza non diagnosticata.
Tuttavia, quando i sintomi sono chiari ed evidenti, la Candida A. nell’uomo si manifesta attraverso un quadro di balanite o balanopsite: è possibile riscontrare arrossamenti e gonfiori a livello del glande, irritazione, prurito, presenza di secrezioni grumose e biancastre, fimosi e dispareunia rendendo la vita sessuale di chi ne è affetto non solo dolorosa, ma anche difficoltosa e talvolta vissuta con disagio nei confronti del partner.
Inoltre non sono esclusi interessamenti cutanei attraverso eruzioni, prurito, bruciore e dolore, soprattutto nelle aree del corpo che tendono allo sfregamento, come l’inguine, il cavo ascellare e le zone interdigitali.
Il trattamento dell’infezione dipende chiaramente dalle aree interessate, e vengono utilizzati come farmaci di prima scelta gli antimicotici ad uso topico e talvolta, nei casi più severi, anche corticosteroidi.
In conclusione, per evitare l’insorgenza dell’infezione e aggravare il quadro patologico è importante mettere in atto i comportamenti preventivi precedentemente menzionati e rivolgersi per eventuali dubbi ad un medico.
Tirocinante: Letizia De Panfilis
Tutor: Fabiana Salucci
Bibliografia:
Candida Albicans , plasticity and pathogenesis. Pouline, D. Critical Reviews in Microbiology (41),2015.
Candida albicans – Biology, molecular characterization, pathogenicity, and advances in diagnosis and control – An update. Dadar, M.,Tiwari, R., Karthik, K., Chakraborty,S.,Shahali, Y. & Dhama, K. Microbial Pathology, 2018.




